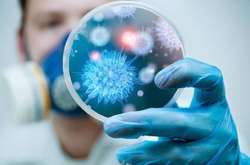
У Китаї третя людина померла через новий коронавірус

грип

У Києві спостерігається зростання кількості хворих на грип
27 сiчня, 2020 13:45

Зокрема, до 31 січня у Бердянську всі школи та дитсадки закрили на карантин
27 сiчня, 2020 00:13

Дитина захворіла на вірус грипу А 20 січня
24 сiчня, 2020 13:23

Карантин у Житомирі оголосили на 10 днів
23 сiчня, 2020 23:57

Інкубаційний період нового коронавірусу становить від двох до 12 діб
23 сiчня, 2020 18:52

Минулого тижня на агрофірмі у Вінницькій області зафіксували пташиний грип
23 сiчня, 2020 13:55

У Міністерстві охорони здоров'я повідомили, скільки людей померли від грипу за останні чотири місяці
З 30 вересня 2019 до 19 січня 2020 перехворіло 6,2% населення України й ушпиталено 67 113 осіб, з них 78,7% - діти у віці до 17 років
22 сiчня, 2020 17:42

У небезпечну зону потрапили дев’ять сіл
22 сiчня, 2020 11:14

Захворювання пневмонією нового типу зафіксували в Таїланді
22 сiчня, 2020 09:09

Осередком нового типу вірусу вважається китайського міста Ухань провінції Хубей
22 сiчня, 2020 07:58

Навчальний процес тимчасово призупинили в Олександрії, Чорткові та Селидові
22 сiчня, 2020 02:20

Представниця ВООЗ у Росії повідомила, що організація бачить у новому вірусі загрозу, яку потенційно можна порівнянти зі свинячим грипом, лихоманкою Ебола і поліомієлітом
21 сiчня, 2020 16:27

У результаті вірусу в Китаї загинули вже шестеро людей
21 сiчня, 2020 14:56

Щоб локалізувати та ліквідувати спалах пташиного грипу, у Вінницьку область поїхала група експертів
21 сiчня, 2020 06:41

На зустрічі мають обговорити, чи є поширення вірусу у Китаї міжнародною надзвичайною ситуацією у сфері охорони здоров'я
21 сiчня, 2020 04:49

У лікарнях із лабораторно підтвердженим грипом знаходяться 29 пацієнтів
20 сiчня, 2020 15:49
Про поширення хвороби, схожої на пневмонію, стало відомо наприкінці грудня 2019 року
20 сiчня, 2020 03:27

У США вже запроваджують додаткові заходи безпеки в аеропортах
19 сiчня, 2020 05:30

з 31 вересня по 12 січня захворіло 2,2 млн людей (5,8% населення), із них 1,5 млн – діти (68% від усіх хворих). Госпіталізовано 61 842 людини
14 сiчня, 2020 14:45

Летальних випадків не зареєстровано
14 сiчня, 2020 11:57

До столичних медичних закладів госпіталізовано 175 хворих на грип
13 сiчня, 2020 16:09


Захворюваність на ГРВІ та грип в Одесі на минулому тижні знизилася на 16,6%, в порівнянні з попереднім тижнем
9 сiчня, 2020 06:08

Жінка звернулася за медичною допомогою на десятий день хвороби
8 сiчня, 2020 20:41

Показник захворюваності на 25,3% менше епідемічного порога по Україні
3 сiчня, 2020 21:44

Протягом останнього тижня в області зареєстровано перші два випадки лабораторно підтвердженого грипу
3 сiчня, 2020 06:48

Виявлений вірус був підтипом високопатогенного пташиного грипу H5N8
2 сiчня, 2020 07:30

Більше 70% хворих — це діти віком до 17 років
23 грудня, 2019 17:43

Спостерігається зниження захворюваності на грип та ГРВІ
23 грудня, 2019 15:55

До уваги одеситів: інформація щодо захворюваності на інфекційні хвороби
18 грудня, 2019 08:27
